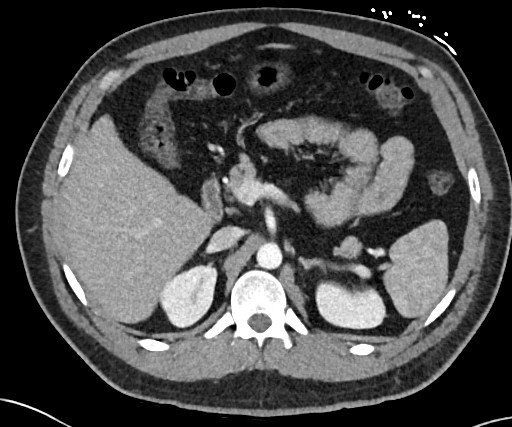

The Three Planes / Views
I like to start this section by highlighting the famous short story of blind men and the elephant. For those of you who aren’t familiar with the story, you can read it here. In summary, each blind man encounters different part of the elephant.
One man felt the elephant’s leg and thought it was like a tree; another touched its trunk and compared it to a snake. Without seeing the whole picture, you may overlook key details. Thus, it is very important to check all 3 planes while evaluating the scan.
The Axial View
The word axis is a Latin in origin, meaning ‘axle’ or ‘pivot’. An axial plane is perpendicular to the long axis of the human body (an imaginary vertical line running from head to toe). In fact, in the early days, CT was known as CAT scan (Computed Axial Tomography).
Picture the image slice moving from the toes to the head; the left side of the screen corresponds to the patient’s right side.
We often start with the axial view, then try to validate what we are seeing with the other 2 views.
The Coronal View
This is also derived from a Latin word corona meaning “crown”. A coronal view follows the plane of the coronal suture of the skull which run across the top of the head, from ear to ear.
This view is best for evaluating long vertical structures like the aorta and IVC. And for checking symmetry across the body’s left and right sides like when evaluating presence of hydronephrosis / hydroureters.

The Sagittal View
This is also derived from another Latin word sagitta meaning “arrow”. A sagittal view follows the plane of the sagittal suture of the skull which run from the front of the skull to the back. In fact, if you look closer, it does looks like an arrow.

This view is useful for assessing anatomical structures with a vertical orientation like the spine, or front-to-back orientation like the central brain, providing important diagnostic details not seen in axial or coronal views.
References:
- StatPearls Publishing. Hounsfield Unit. [Internet]. Treasure Island (FL): StatPearls Publishing; 2023 Mar 6 [cited 2024 May 22]. Available from: https://www.ncbi.nlm.nih.gov/books/NBK547721/
- Radiopaedia. Windowing (CT). [Internet]. Radiopaedia.org; 2017 Mar 22 [updated 2024; cited 2024 May 22]. Available from: https://radiopaedia.org/articles/windowing-ct
- TeachMeAnatomy. Basic Principles of CT Scans. [Internet]. TeachMeAnatomy.info; [cited 2024 May 22]. Available from: https://teachmeanatomy.info/the-basics/imaging/computed-tomography-ct-scans/
- Life in the Fast Lane (LITFL). Abdominal CT: Windows basics. [Internet]. LITFL; 2024 Aug 21 [cited 2024 May 22]. Available from: https://litfl.com/abdominal-ct-windows-basics/
- Radiology Cafe. CT Overview: Radiology Basics. [Internet]. Radiology Cafe; 2021 Oct 10 [cited 2024 May 22]. Available from: https://www.radiologycafe.com/radiology-basics/imaging-modalities/ct-overview/
Recent Posts
- Piezo 101: Squeezing Electricity Since 1880 April 16, 2026
- Central Venous Access Device (CVAD) April 11, 2026
- Pneumonia – CXR March 28, 2026
- Right Ventricular Systolic Function March 7, 2026
- Right Ventricular Dimension February 27, 2026
